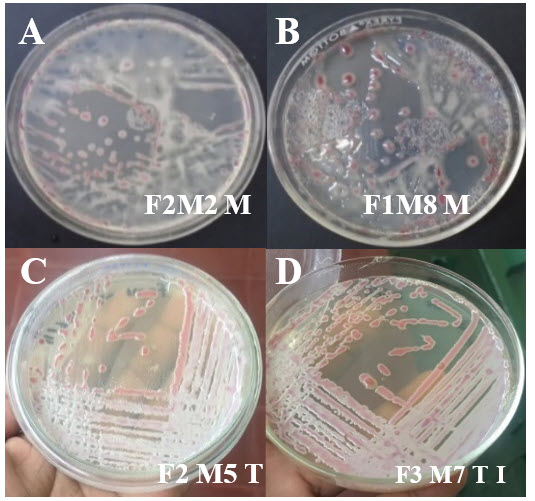
Aislados de Ralstonia solanacearum  

en medio de cultivo TZC 1 %.
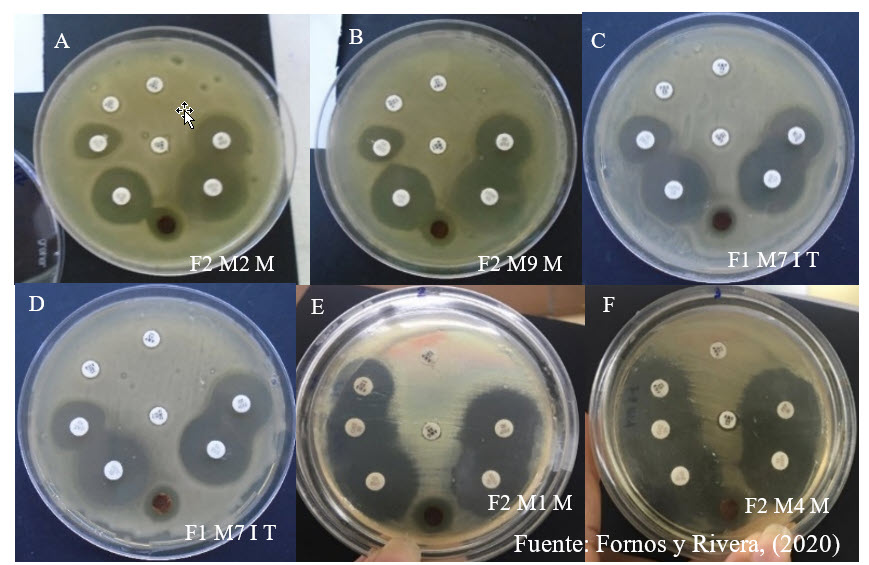
Aislados
de R. solanacearum
con fenotipos AmpC hiperproducido 

(A, B, C y D) y fenotipos salvajes (E y F) aislados de las zonas de
muestreo.

Ciencia de las Plantas
Razas, biovares y mecanismos de resistencia de aislados de Ralstonia solanacearum en el cultivo de papa (Solanum tuberosum L.) en Nicaragua
Races, biovars and resistance mechanisms of Ralstonia solanacearum isolates in potato crops (Solanum tuberosum L.) in Nicaragua
La Calera
Universidad Nacional Agraria, Nicaragua
ISSN: 1998-7846
ISSN-e: 1998-8850
Periodicidad: Semestral
vol. 21, núm. 37, 2021
Recepción: 20 Marzo 2020
Aprobación: 14 Octubre 2021

Resumen: La papa (Solanum tuberosum L.) es el tercer cultivo alimenticio más importante del mundo en términos de consumo humano, después del arroz y del trigo, es un alimento básico para países desarrollados como Europa y Estados Unidos. Este cultivo es afectado por problemas fitosanitarios, entre los que sobresale Ralstonia solanacearum. El objetivo de este estudio fue identificar mediante prueba fenotípica los mecanismos de resistencia de la bacteria Ralstonia solanacearum, aislada del cultivo de papa (S. tuberosum L.). La colecta de muestras se realizó en fincas de la reserva natural Miraflor y Tisey del departamento de Estelí. La bacteria fue aislada a partir de tejido vegetal mediante la prueba de flujo bacteriano y por técnica de dilución a partir de las muestras de suelo. La identificación de biovares se realizó con pruebas individuales de carbohidratos y la caracterización de razas fue mediante la prueba de hipersensibilidad Ralstonia solanacearum en hojas de tabaco. Se identificaron 19 aislados con características de Ralstonia solanacearum que manifestaron reacciones positivas a las pruebas de Oxidasa, Catalasa y KOH 3%, además se caracterizaron por su crecimiento acuoso, colonias grandes, blancas y centro de color rosado en el medio agar cloruro de tetrazolium (TZC 1%), con la prueba individual de azúcares se identificaron 14 aislados de R. solanacearum, como biovar 1, y los cinco restantes como biovar 3. Las reacciones en hojas de tabaco después de la infiltración de la bacteria mostraron que los 19 aislados de R. solanacearum pertenecen a la raza 1. Se identificaron 12 aislados de R. solanacearum con mecanismo de resistencia AmpC hiperproducido y siete aislados considerados como salvajes.
Palabras clave: infiltración, carbohidratos, antibiograma, AmpC, hipersensibilidad.
Abstract: Potato (Solanum tuberosum L.) is the fourth crop grown in more than one hundred countries and the third most important food crop in the world in terms of human consumption, after rice and wheat, it is a staple food for developed countries such as Europe and USA. This crop is affected by phytosanitary problems, in which Ralstonia solanacearum stands out. The objective of this study was to identify by phenotypic test, resistance mechanisms of the bacterium Ralstonia solanacearum, isolated from the potato crop (S. tuberosum L.). The collection of samples was carried out on farms in the Miraflor and Tisey nature reserve in the department of Estelí. The isolation of the bacteria from plant tissue by means of the bacterial flux test and the soil samples were subjected to the serial dilution method. The identification of biovars was carried out with individual tests of carbohydrates and the characterization of races was by means of the infiltration test of Ralstonia solanacearum in tobacco leaves. 19 isolates with characteristics of Ralstonia solanacearum were identified that showed positive reactions to the Oxidase, Catalase and 3% KOH tests, in addition they were characterized by their aqueous growth, large, white colonies and a pink center in the tetrazolium chloride agar medium (TZC 1%), with the individual sugar test, 14 isolates of R. solanacearum were identified as biovar 1, and the remaining five as biovar 3. of R. solanacearum belongs to race 1. 12 isolates of R. solanacearum were identified with hyperproduced AmpC resistance mechanism and seven isolates cataloged as wild.
Keywords: Infiltration, carbohydrates, antibiogram, AmpC, hypersensitive.
La papa (Solanum tuberosum L.) es el cuarto cultivo más importante del mundo, después del arroz, maíz y el trigo, debido a sus propiedades alimenticias y su rápido crecimiento. Sus tubérculos son parte de la dieta alimenticia de millones de personas en todo el mundo (Lim, 2016). En Nicaragua, la papa representa un cultivo de mucha importancia después de los granos básicos y se cultiva en zonas altas de Estelí, Jinotega y Matagalpa. Según el Instituto Nicaragüense de Tecnología Agropecuaria (INTA, 2020), el consumo per cápita en nuestro país es de ocho kilogramos anuales, se siembra entre 800 y 1 200 hectáreas con una producción que satisface entre el 35 % y el 40 % de la demanda nacional.
El cultivo de papa es más apto para cultivarse a altitudes entre 1 500 y 2 500 msnm, pero también puede cultivarse en alturas menores. Se adapta mejor a suelos francos, franco-arenosos, franco-limosos y franco-arcillosos, de textura liviana, con buen drenaje y con una profundidad efectiva (mayor de 0.50 m), que permitan el libre crecimiento de los estolones, tubérculos y faciliten la cosecha. Las temperatura que favorece el desarrollo de tuberculos es de 18°C a 25°C,con una variacion mínima 10 °C entre el día y la noche (Román y Hurtado, 2002).
A pesar de la importancia que tiene el cultivo de papa, este se ve afectado por diversos factores que reducen el rendimiento y calidad de los tubérculos, y elevan los costos de producción. La papa es susceptible a más de 100 enfermedades causadas por diversos organismos como hongos, bacterias, micoplasmas y virus, y problemas fisiológicos (Esquivel, 2017).
La marchitez bacteriana causada por Ralstonia solanacearum [Smith (1896) Yabuuchi et al., 1996], es una de las enfermedades más importantes en el cultivo de papa. Su distribución está registrada desde el sur de Estados Unidos hasta Argentina (Ríos, 2007). Actualmente está ampliamente distribuida en zonas tropicales y subtropicales, esto representa una limitante para la producción, no solo de papa, sino también de maní, tabaco, banano, tomate y otros cultivos. Se estima que las pérdidas económicas exceden los USD 950 millones anuales (Esquivel, 2017).
Los síntomas iniciales inducidos por R. solanacearum consisten en marchitamiento de las hojas más jóvenes en las partes terminales de las ramas durante las horas más calurosas del día. En esta etapa, sólo una o la mitad de una rama se puede marchitar y las plantas parecerán recuperarse por la noche, cuando la temperatura es más fresca. A medida que la enfermedad se desarrolla bajo condiciones favorables, la planta entera se puede marchitar rápidamente y desecarse, aunque las hojas secas se mantengan verdes, conduciendo a marchitamiento general, amarillamiento del follaje, y finalmente a la muerte de la planta (Champoiseau et al., 2009).
Tradicionalmente las cepas de R. solanacearum son clasificadas en cinco razas, de acuerdo con su gama de hospederos y en seis biovares (Bv1, Bv2, Bv3, Bv4, Bv5 y Bv6), según su capacidad metabólica para la utilización de diversas fuentes de carbono relacionados con sus propiedades bioquímicas; es una devastadora enfermedad que afecta varios cultivos hortícolas y en solanáceas es de importancia a nivel mundial y nacional. La capacidad de supervivencia del patógeno y la ocurrencia de infecciones latentes hace que el diagnóstico tenga una importante función en la prevención de la enfermedad (Naranjo y Martínez, 2013).
La resistencia bacteriana es un problema continuo y en aumento, cuando un microorganismo presenta más de un mecanismo de resistencia y tiene la facultad de transmitirlo, no solo a su descendencia, sino a otras bacterias de su misma o diferente especie (Moreno et al., 2009). Las bacterias, por su capacidad de adaptación, pueden desarrollar mecanismos de resistencia a los antibióticos; uno de los mecanismos más utilizados por las bacterias es disminuir la presencia de los antibióticos en su interior, modificando su permeabilidad, esto altera su mecanismo de transporte activo en la membrana celular y genera el mecanismo de eliminación activa del antibiótico. Existe resistencia natural en las bacterias si carecen de sitios diana para el antibiótico (falta de pared celular y ribosomas) y resistencia adquirida, que son modificaciones de la carga genética de la bacteria que aparecen por mutación cromosómica o por mecanismos de transferencia genética (Duarte-Raya y Granados-Ramírez, 2012). Existen métodos para detección de mecanismos de resistencias bacterianas, como micro diluciones en caldos, prueba de difusión de discos de Kirby Bauer, prueba de aproximación de doble disco, prueba de asociación con ácido clavulánico y el método E-test (Echevarría, 1998).
En Nicaragua no existen estudios de mecanismos de resistencia en bacterias fitopatógenas, pero debido al manejo de la enfermedad, principalmente al uso de antibióticos, probablemente existen razas y biovares resistentes. Por tanto, el objetivo de esta investigación es aportar información sobre las razas, biovares y mecanismos de resistencia de R. solanacearum en el cultivo de papa.
MATERIALES Y MÉTODOS
El estudio se realizó de septiembre del 2020 a febrero del 2021 en el laboratorio de microbiología e invernadero de la Universidad Nacional Agraria (UNA), Managua, Nicaragua.
El estudio se realizó en dos etapas, en la primera se colectaron muestras de tejido vegetal y de suelo, para aislar e identificar a R solanacearum; en la segunda etapa se realizaron pruebas bioquímicas para la identificación de biovares, caracterización de razas y determinación de mecanismos de resistencia de R solanacearum.
Colecta de muestras
Para la obtención de las muestras se seleccionaron plantas que presentaban los síntomas característicos de marchitamiento por R. solanacearum tales como marchitez a nivel de follaje, coloración verde pálida en hojas y caída de las hojas básales seguidos por la marchitez total de la planta (Ríos, 2007). El muestreo se realizó en dos reservas naturales del departamento de Estelí, ubicadas en la parte central norte del país. Se colectaron 22 muestras en la Reserva Natural Tisey (154 km al norte de Managua, capital de Nicaragua) y 26 muestras en la Reserva Natural Miraflor a 192 km de Managua. Las variedades de papa presentes en estas fincas fueron Granola, Hactri, Evora y Picasso. Las muestras consistieron en tejido vegetal y suelo; que se colocaron en bolsas plásticas, con cierre hermético dentro de una hielera para ser trasladadas al laboratorio de microbiología y fueron almacenadas a 4 oC, previamente al aislamiento bacteriano.
Aislamiento de R. solanacearum a partir de muestras de tejido y suelo
Se realizó la prueba de flujo bacteriano, la que consistió en realizar cortes transversales, desinfectarlos con hipoclorito de sodio al 1 % y lavarlos con agua destilada estéril (ADE). Posteriormente los trozos de tallo se sumergieron en ADE y se observó la presencia o ausencia de un hilo blanco, que consiste en el flujo bacteriano (Perea et al., 2011). Con las muestras de suelo se utilizó la técnica de dilución seriada. Se preparó una solución madre a partir de 10 g de suelo y 90 ml de agua destilada estéril, en un Erlenmeyer de 150 ml, a partir de la cual se prepararon las diluciones 10-3, 10-4 y 10-5 (Agrios, 1997).
Identificación de R. solanacearum
El flujo bacteriano obtenido del tejido vegetal fue inoculado con una asa bacteriológica en el medio de cultivo agar cloruro de tetrazolium (TZC); las placas petri fueron incubadas a 30 °C. Después de 48 horas de incubación se observaron las características macroscópicas (tamaño, forma, superficie, bordes, color y producción de pigmento) del crecimiento bacteriano (Kelman, 1954). En el caso de aislamiento de suelo se utilizaron las diluciones 10-3, 10-4 y 10-5, las que fueron inoculadas el medio de cultivo agar cloruro de tetrazolium (TZC 1 %), depositando la cantidad de 100 µl en cada plato petri. Se realizaron pruebas bioquímicas de oxidasa, catalasa y KOH 3 % para determinar la presencia de la bacteria según su reacción (Schaad et al., 2001).
Identificación de biovares y razas
Para la identificación de biovares se realizó prueba individual de carbohidratos, observando las reacciones de oxidación–fermentación a partir de los disacáridos Lactosa, Maltosa y Celobiosa, y la oxidación de las hexosas alcohólicas Dulcitol, Manitol y Sorbitol. Los tubos de ensayo que contenían los carbohidratos fueron examinados a los 3, 7, 14 y 28 días después de la inoculación. El cambio de coloración en el medio de purpura a amarillo indicaron resultados positivos (Schaad et al., 2001; French et al., 1995).
Las razas fueron caracterizadas en plantas individuales de tabaco (prueba de hipersensibilidad), se preparó una suspensión bacteriana a partir de cultivos puros con 24-48 horas de incubación y agua destilada estéril hasta obtener una concentración de 1 x 108 UFC (unidades formadoras de colonia), (0.5 solución escala Mackfarland), posteriormente se hicieron orificios sobre el haz de la hoja en zonas intervenales con una aguja hipodérmica N° 29; se inoculó la suspensión bacteriana con una jeringa sin aguja, apoyando la jeringa sobre la superficie de la hoja y presionando por debajo con los dedos. Los resultados se monitorearon en un periodo de 12 a 96 horas, observando síntomas como clorosis, marchitamiento y reacción de hipersensibilidad. Según Lozano y Sequeira (1970) la raza 1 causa clorosis a los dos días después de la inoculación y marchitamiento típico después de 7-8 días, la raza 2 causa clorosis a los dos días después de la inoculación y marchitamiento típico después de 7-8 días, mientras que la raza 3 provoca reacción hipersensitiva 12-24 horas después de la inoculación.
Identificación fenotípica de mecanismos de resistencia bacteriana
Se realizó mediante prueba de difusión de discos de Bauer et al. (1966) que consiste en la medición y observación visual del tamaño y forma de los halos de inhibición producida por la sinergia entre los discos de antibióticos Cefoxitina (FOX), Cefepima (FEP), Ceftazidima (CAZ) Amoxicilina más ácido clavulánico (AMC), Ampicilina (AMP), Meropenem (MER), Imepenem (IMP) e inductor EDTA. Los aislados de R. solanacearum con ausencia de halo o halo menor a 14 mm indica que son resistentes a Cefoxitina, debido a la presencia de AmpC; en el caso de observar aplastamiento en la zona de sinergia con AMC indica resistencia a CAZ y a FEP, debido a la presencia de betalactamasas de espectro extendido (BLEE). La utilización en este estudio de Meropenem e Imepinem fue para descartar la posibilidad de aislados con presencia de Carbapenemasas (Clinical and Laboratory Standards Institute, 2016).
RESULTADOS Y DISCUSIÓN
Identificación de biovares
Se obtuvieron 29 muestras negativas de R. solanacearum y 19 aislados positivos, 11 aislados de la Reserva Natural Miraflor y ocho de la Reserva Natural Tisey; ya que manifestaron reacciones positivas a las pruebas de oxidasa, catalasa y KOH 3 %, además se caracterizaron macroscópicamente por las colonias de crecimiento acuoso grandes, blancas y centro de color rosado en el medio cultivo TZC al 1 % de Kelman. Estos permitieron identificar 14 aislados pertenecientes al biovar 1, los cuales mostraron reacciones negativas en cada uno de los carbohidratos utilizados (Lactosa, Maltosa, Celobiosa, Dulcitol, Manitol y Sorbitol), y cinco identificados como biovar 3 que mostraron reacciones positivas en cada carbohidrato, según French et al. (1995). En este estudio tuvo mayor incidencia el biovar 1 en comparación con el biovar 3.
Caracterización de razas de Ralstonia solanacearum
Los resultados de la prueba de hipersensibilidad en planta de tabaco (Lozano y Sequeira 1970), indican que pasadas 48 horas después de la infiltración se observó clorosis en la zona infiltrada, ocho días después se observó marchitamiento de las plantas. Estas características indican que los aislados pertenecen a la raza 1.

Los resultados de este estudio tienen similitud con los datos obtenidos por Ríos (2007), quien determinó mediante pruebas de fermentación-oxidación de carbohidratos e inoculación de plantas de tabaco la presencia de raza 1, biovar 1 y biovar 3 en el cultivo de papa en zonas de Estelí, y la caracterización de razas y biovares de R. solanacearum realizado por Díaz (2005) en Nicaragua, determinó que 20 aislados pertenecían a la raza 1 biovar 3 y siete pertenecían a la raza 2 biovar 3 prevaleciendo en los sitios muestreados el biovar 3.
Estudio realizado por Chavarro y Ángel (2006), en 200 muestras colectadas del cultivo de papa (Solanum tuberosum L.) y plátano (Musa paradisiaca), mediante la técnica NCM-ELISA, determinaron 36 aislamientos de R. solanacearum. Las razas y biovares se determinaron mediante reacción en cadena de la polimerasa (PCR) y secuenciación, obteniendo como resultado agrupaciones correspondientes a la raza 3, biovar 2, en aislados de papa (Solanum tuberosum L.) y agrupaciones de raza 2, biovar 1 en aislamiento de plátano (Musa paradisiaca).
Determinación fenotípica de mecanismo de resistencia
Se encontró que 12 aislados, ocho aislados de la reserva natural Miraflor y cuatro de la reserva natural Tisey, no mostraron halos de inhibición indicando la presencia del fenotipo AmpC hiperproducido (derreprimido) lo que corresponde a resistencia a Cefoxitina; mientras tanto, siete aislados fueron susceptibles a los antibióticos utilizados para determinar mecanismos de resistencia y catalogados como aislados salvajes. No se encontró presencia de aislados de R. solanacearum con presencia de Betalactamasas de espectro extendido (BLEE).
Según Schmidtke y Hanson (2006), se han encontrado en plás-midos genes AmpC de diferentes orígenes genéticos, incluidos C. freundii y M. morganii. El movimiento de estos genes en plásmidos aumentó la prevalencia de este mecanismo de resistencia mediante la diseminación del gen en organismos gramnegativos que naturalmente no portan genes que codifiquen AmpC, como Salmonella spp. y Klebsiella pneumoniae, además confirma que el gen AmpD es un mecanismo involucrado en la sobreproducción de AmpC que conduce a un fenotipo dereprimido y una enzima importante en la vía de reciclaje de la pared célula.
Tans-Kersten et al. (2000), demuestran la presencia del gen AmpD en la bacteria Ralstonia solanacearum, que codifica para la enzima AmpD, que consiste en una amidasa citoplasmática (N-acetilmuramil-L-alanina amidasa), además proponen la posibilidad que AmpD realice otras funciones desconocidas en la célula bacteriana, tales como factor de virulencia para el marchitamiento bacteriano o bien podría funcionar como autolisina durante patogénesis de la marchitez bacteriana.
CONCLUSIONES
De acuerdo con la prueba de hipersensibilidad, todos los aislados de R. solanacearum obtenidos en las reservas naturales de Miraflor y Tisey presentaron clorosis 48 horas después de la inoculación y marchitamiento a los siete y ocho días después de la inoculación, indicando que corresponde a la raza 1. De los aislados R. solanacearum obtenidos, 14 corresponden al biovar 1 y 5 al biovar 3 y se identificron 12 aislados de Ralstonia solanacearum con mecanismo de resistencia AmpC hiperproducido y siete aislados catalogados como salvajes, se presume que dicho mecanismo de resistencia identificado en los aislados de R. solanacearum es adquirido, y posiblemente esté relacionado con una mutación en el DNA del plásmido.
Referencias
Agrios, G. W. (1997). Fitopatología. Academic Press.
Bauer, A. W., Kirby, W. M., Sherris, J. C., y Turck, M. (1966). Antibiotic susceptibility testing by a standardized single disk method. American journal of clinical pathology, 45(4), 493–496. https://doi.org/10.1093/ajcp/45.4_ts.493
Champoiseau, P. G., Jones, J. B., y Allen, C. (2009). Ralstonia solanacearum race 3 biovar 2 causes tropical losses and temperate anxieties. Plant Health Progress, 10(1). https://doi.org/10.1094/PHP-2009-0313-01-RV
Chavarro, M., y Ángel, J. (2006). Establecimiento de un sistema diagnóstico para la detección de Ralstonia solanacearum y diferenciación genética utilizando marcadores moleculares RAPD. Revista Colombiana de Biotecnología, 8(1), 14-31. https://revistas.unal.edu.co/index.php/biotecnologia/article/view/503
Clinical and Laboratory Standards Institute. (2016). Performance standards for antimicrobial susceptibility testing.
Díaz, U. (2005). Caracterización preliminar de razas y biovares de Ralstonia solanacearum (E.F. Smith) Yabuuchi et al., en Nicaragua. La Calera, 5(5). 24-31. https://lacalera.una.edu.ni/index.php/CALERA/article/view/67
Duarte-Raya, F., y Granados-Ramírez, M. (2012). Resistencia antimicrobiana de bacterias en un hospital de tercer nivel. Revista Médica del Instituto Mexicano del Seguro Social, 50(3), 289- 300. https://www.redalyc.org/pdf/4577/457745495012.pdf
Echevarría Zarate, J. (1998). Resistencia bacteriana. Revista Médica Herediana, 9(2), 53-55. https://doi.org/10.20453/rmh.v9i2.2384
Esquivel Solano, M. A. (2017). Evolución de la susceptibilidad a la marchitez bacteriana (Ralstonia solanacearum) en genotipos promisorios y parientes silvestres de la papa en Costa Rica [Tesis de grado, Universidad de Costa Rica]. Repositorio del SIBDI-UCR. http://repositorio.sibdi.ucr.ac.cr:8080/jspui/handle/123456789/3425
French, E., Gutarra, L., y Aley, P. (1995). Medios de cultivo para el aislamiento e identificación de Pseudomonas solanacearum. Centro Internacional de la Papa (CIP).
Instituto Nicaragüense de Tecnología Agropecuaria. (2020). Recomendaciones para la producción de papa en la época de primera 2020. https://inta.gob.ni/wp-content/uploads/2020/04/Recomendaciones-produccion-Papa-DEPARTAMENTAL-ESTELI-2020.pdf
Kelman, A. (1954). The relationship of pathogenicity in Pseudomonas solanacearum to colony appearance on a tetrazolium médium. Phytopathology, 44, 693-695.
Lim, T. K. (2016). Solanum tuberosum. En T. K. Lim (Ed.), Edible Medicinal and Non-Medicinal Plants, (pp. 12-93). Springer. https://doi.org/10.1007/978-3-319-26065-5_2
Lozano, J., y Sequeira, L. (1970). Differentiation of races of by a leaf infiltration tecnique. Phytopathology, 60(5), 833-838. https://www.apsnet.org/publications/phytopathology/backissues/Documents/1970Articles/Phyto60n05_833.pdf
Moreno, C., González, R., y Beltrán, C. (2009). Mecanismos de resistencia antimicrobiana en patógenos respiratorios. Revista de Otorrinolaringología y Cirugía de Cabeza y Cuello, 69(2), 185–192. http://doi.org/10.4067/S0718-48162009000200014
Naranjo, E., y Martínez, Y. (2013). Avances en el diagnóstico de la marchitez bacteriana (Ralstonia solanacearum): situación actual y perspectivas en Cuba. Revista de Protección Vegetal, 28(3), 160–170. http://scielo.sld.cu/scielo.php?script=sci_abstract&pid=S1010-27522013000300001
Perea, S., García, R., Allende, R., Carrillo, J., León, J., Valdez, B., y López, F. (2011). Identificación de razas y biovares de aisladas de plantas de tomate. Ralstonia solanacearum. Revista Mexicana de Fitopatología, 29(2). 98-108. https://www.redalyc.org/pdf/612/61222864002.pdf
Ríos, G. (2007). Distribución y variabilidad de Ralstonia solanacearum E.F. Smith, agente causal de marchitez bacteriana en el cultivo de papa (Solanum tuberosum L), en tres departamentos del norte de Nicaragua (Estelí, Matagalpa y Jinotega) [Tesis de grado, Universidad Nacional Agraria]. Repositorio Institucional UNA. https://repositorio.una.edu.ni/1366/1/tnh20r586.pdf
Román, M., y Hurtado, G. (2002). Cultivo de la papa. Centro Nacional de Tecnología Agropecuaria y Forestal. http://www.centa.gob.sv/docs/guias/hortalizas/Guia%20Papa.pdf
Schaad, N. W., Jones, J. B., y Chun, W. (2001). Laboratory guide for the identification of plant pathogenic bacteria. American Phytopathological Society (APS press).
Schmidtke, A., y Hanson, N. (2006). Model system to evaluate the effect of ampD mutations on AmpC- mediated β-lactam resistance. Antimicrob Agents and Chemother, 50(6), 2030-2037. https://doi.org/10.1128/AAC.01458-05
Tans-Kersten, J., Gay, J., y Allen, C. (2000). Ralstonia solanacearum AmpD is required for wild-type bacterial wilt virulence. Molecular Plant Pathology, 1(3), 179–185. https://doi.org/10.1046/j.1364-3703.2000.00023.x
Notas de autor

